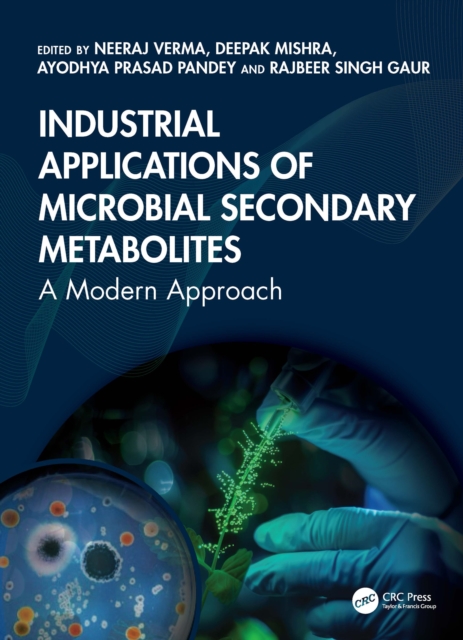
Industrial Applications of Microbial Secondary Metabolites

Industrial Applications of Microbial Secondary Metabolites
Will be available from 02.02.2026
This comprehensive volume presents the fascinating and diverse world of microbial secondary metabolites, exploring their biosynthesis, ecological roles, and wide-ranging applications in biotechnology, pharmacy, agriculture, and various other industries. The initial chapters provide a foundational overview of microbial secondary metabolites and their immense value. The subsequent chapters discuss m...
Read more
E-book
epub
Price
52.99 £
This comprehensive volume presents the fascinating and diverse world of microbial secondary metabolites, exploring their biosynthesis, ecological roles, and wide-ranging applications in biotechnology, pharmacy, agriculture, and various other industries. The initial chapters provide a foundational overview of microbial secondary metabolites and their immense value. The subsequent chapters discuss m...
Read more